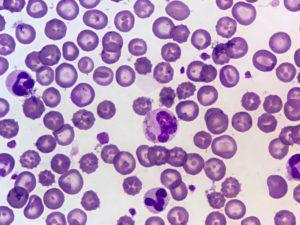
Canine Distemper Virus Cytoplasmic

Sensitising dogs with canine allogenic blood has enabled the identification of Dog Erythrocyte Antigens (DEA), which are clinically important regarding blood transfusion incompatibilities. In spite of the classification of eight DEAs in 1974, DEAs remain poorly characterised and only reagents for four DEAs are commercially available. In veterinary clinical practice, blood type incompatibilities have been documented using hemolytic transfusion reactions and incompatible agglutination crossmatch test results from dogs that require blood transfusions.
Recent flow cytometry and strip kit typing studies with monoclonal antibodies reveal that dogs are either positive or negative for a specific DEA except DEA 1, where dogs have been observed to possess a spectrum of expression ranging from weakly DEA 1-negative to strongly DEA 1-positive. Additionally, there is clinical evidence indicating the development of alloantibodies to unknown red blood cells antigens, distinct from conventional DEAs.
A recent study has characterized two DEAs named as Kai 1 and Kai 2 by using monoclonal antibodies (mAb) produced by mouse hybridoma techniques. The researchers obtained two mAbs against two erythrocytic membrane antigens which could be present or absent but did not coexist in any dogs. The two mAbs and corresponding antigens were biochemically characterized by enzyme-linked immunosorbent assay (ELISA), immunoblot and affinity chromatography. Their antigenicity was examined in dogs after receiving inadvertently mismatched blood transfusions. Researchers identified an anti-Kai 1 mAb, IgM kappa isotype, which was a stronger agglutin compared to the anti-Kai 2 mAb, IgG3 lamda isotype, against the Kai+ erythrocytes. Researchers also demonstrated that Kai 1 negative and/or Kai 2 negative dogs developed anti-Kai 1 and anti-Kai 2 alloantibodies, respectively, when transfused with mismatched blood demonstrating the clinical importance of these Kai blood groups. This demonstrates that monoclonal anti-Kai reagents can be utilised for typing in clinical setting, beyond the currently recommended DEA 1, in order to avoid sensitization and transfusion reactions.
This study shows the existence of other dog red blood antigens than those originally described. Furthermore, this is the first discovery of canine blood types by screening monoclonal antibodies. Blood typing beyond DEA 1 typing including Kai may be helpful to explain blood type incompatibilities in previously transfused dogs and donors.
Research Article: Lee et al. 2017. Kai 1 and Kai 2: Characterization of these dog erythrocyte antigens by monoclonal antibodies. PLoS ONE.
Journal Article by Giselle G. Ingratta.